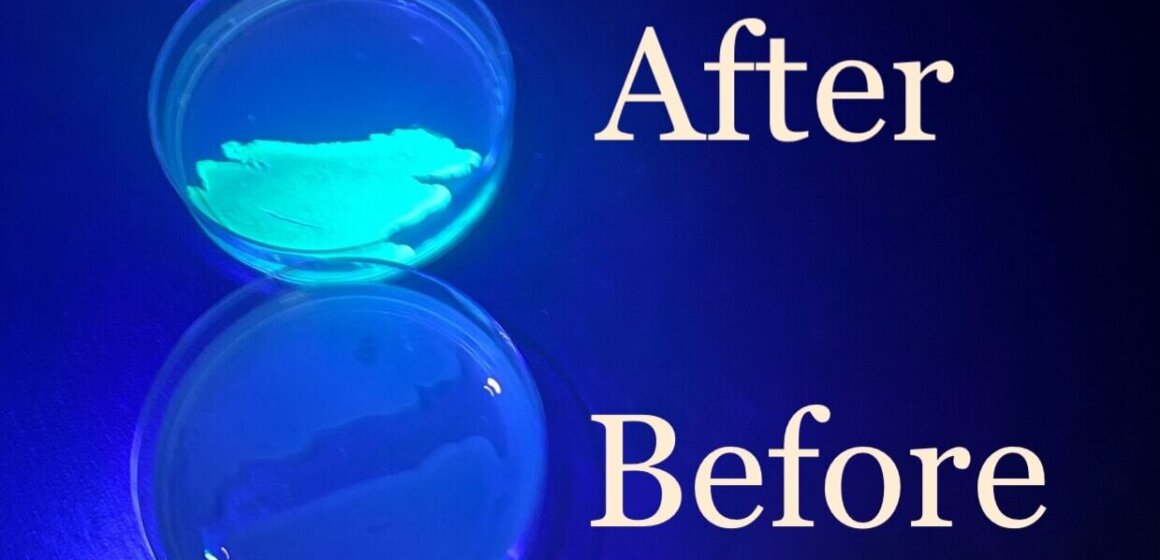
AP Bio GMO

Bacterial Transformation
Students in our AP Biology lab course genetically engineered E. coli to express the Green Fluorescent Protein (GFP) from the bioluminescent jellyfish, Aequorea Victoria. By using the same procedure molecular biologists use to create designer proteins, they transformed the bacteria to now glow green under UV light.